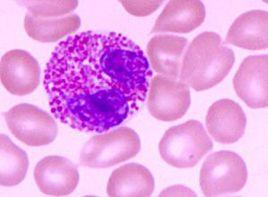
嗜酸細胞增加 嗜酸細胞增加

原因
細胞因子IL-5能特異地促進嗜酸粒細胞的發育、分化和成熟,是引起嗜酸粒細胞生成增加的重要因素。正常情況下嗜酸粒細胞主要留居於組織中如呼吸道、胃腸道和泌尿生殖道的上皮細胞與深層組織之間的界面上,壽命可長達數周。血中嗜酸細胞數並不能確切反映組織中嗜酸粒細胞的多少。本症主要是骨髓內嗜酸粒細胞生成增多,以致血液和組織中嗜酸粒細胞過份積聚。嗜酸粒細胞漿內含有特異的嗜酸性陽離子蛋白,決定了細胞的染色和功能特徵。嗜酸粒細胞除具吞噬功能外,還有一系列的免疫功能,具有細胞毒作用的陽離子顆粒蛋白對不能被吞噬的蠕蟲類寄生蟲有殺傷作用,即能參與宿主抗寄生蟲感染。嗜酸粒細胞合成的脂類介質如:環內過氧化物、白三烯C4、血小板活化因子等能引起呼吸道平滑肌收縮,黏膜分泌增加,血管通透性改變。嗜酸及嗜中性粒細胞的浸潤,同時可引起肥大細胞和嗜鹼粒細胞脫顆粒釋放過敏介質,參與過敏性疾病的發生。嗜酸粒細胞大量破壞後,其顆粒中的蛋白質聚合而成的夏-萊(Charcot-Leyden)晶體可見於患者的痰、糞和組織內,是嗜酸粒細胞相關疾病的標誌。嗜酸粒細胞參與正常免疫防禦反應的同時,也能造成組織損傷。
檢查
血象常見貧血和血小板減少,白細胞數明顯增高,可達(50~200)109/L,血片中嗜酸性粒細胞占20%~90%,多數在60%以上,其中嗜酸性中幼粒及晚幼粒增多為主。原粒及早幼粒少見。周圍血液中嗜酸粒細胞絕對值大於400~450/mm3,血中嗜酸粒細胞絕對值增高即可診斷本症。關鍵是病因診斷,必須詳細全面檢查,以確定原發疾病。對診斷不肯定者應定期隨訪。
鑑別診斷
(一)寄生蟲感染是嗜酸粒細胞增多最常見的原因。單細胞的原蟲感染一般不引起嗜酸粒細胞增高,而多細胞的蠕蟲、吸蟲可引起嗜酸粒細胞增多,其程度與蟲體,特別是幼蟲侵入組織的數量和範圍相平行。限於腸道腔內的感染如:蛔蟲、絛蟲,一般不引起嗜酸粒細胞增多。臨床對原因不明的嗜酸粒細胞增多者必須仔細了解患者生活環境及飲食史,檢查糞便以發現蟲卵或幼蟲。但有的寄生蟲如旋毛蟲、絲蟲感染,並不能從糞便中檢出。因而有寄生蟲接觸史者,有哮喘發作,移位性肺炎,肝腫大等蚴蟲移行征表現者,必須進行有關的血液和組織學檢查,以明確病因。
(二)變態反應性疾病包括過敏性鼻炎、支氣管哮喘、蕁麻疹、血管神經性水腫、藥物過敏反應等均可出現嗜酸粒細胞增多。藥物過敏反應可僅表現為嗜酸粒細胞增多,一旦出現藥物熱和器官受累時應立即停藥。藥物引起的間質性腎炎,嗜酸粒細胞不但在血液內增多,而且在尿液中亦可被檢出。
(三)感染性疾病急性細菌和病毒感染常可引起嗜酸粒細胞增高,在恢復期大多回復正常。有的真菌(曲菌和球孢子菌)病和慢性結核病亦可見嗜酸粒細胞增多。
(四)特發性高嗜酸粒細胞綜合徵(idiopathichypereosinophilicsyndrome)本徵是以嗜酸粒細胞持續、過量地生成為特徵的骨髓增生性疾病。其診斷標準為:①血中嗜酸粒細胞絕對計數1500/mm3,持續半年以上;②缺乏明確的引起嗜酸粒細胞增多的病因;③有器官受累的症狀和體徵。由於患者主要受累的器官不一,臨床表現多樣,可有發熱、咳嗽、胸痛、心悸、氣短、神經精神症狀、瘙癢、皮疹、肝脾和淋巴結腫大、四肢末端水腫等。最嚴重的是心內膜下血栓形成和纖維化,腱索纖維化,導致房室瓣返流,最終發生進行性的充血性心力衰竭。超聲心動圖探查可用於診斷和監測。來自心臟的栓塞、瀰漫性腦病、周圍神經病,特別是多發性單神經炎是神經系統受累的主要表現。皮膚、呼吸系統和消化系統亦常受累。主要臟器累及者預後差。表現為血管性水腫者,心臟常不被累及,預後較好。
(五)腫瘤嗜酸粒細胞白血病罕見。該病除白血病常見的發熱、貧血、肝脾和淋巴結腫大外,心、肺、神經系統和皮膚浸潤症狀比較突出,因而亦有將其歸入高嗜酸粒細胞綜合徵者(詳見少見和特殊類型白血病)。
慢性粒細胞白血病、少數急性非淋巴細胞白血病、霍奇金病、癌腫特別是起源於能產生粘蛋白的上皮細胞癌、蕈樣肉芽腫、血管免疫母細胞淋巴結病亦常伴嗜酸粒細胞增多。
(六)皮膚病多種皮膚病包括腫瘤、天皰瘡、皰疹性皮炎、剝脫性皮炎、濕疹、牛皮癬、疥瘡、血管神經性水腫、蕁麻疹等及妊娠期的某些皮膚病均可伴嗜酸粒細胞增多。
(七)肺嗜酸粒細胞浸潤症(pulmonaryinfiltrationwitheosinophilia,PIE)這是一組並不少見的疾病。其發病機制多與異常的免疫反應有關,但病因尚不確切。臨床特點是咳嗽、胸悶、氣急。血嗜酸粒細胞增多。X線檢查肺部有斑片雲霧狀的散在或遊走性浸潤灶和肺組織活檢示嗜酸粒細胞增多為其診斷要點。周圍血液中嗜酸粒細胞絕對值大於400~450/mm3,血中嗜酸粒細胞絕對值增高即可診斷本症。關鍵是病因診斷,必須詳細全面檢查,以確定原發疾病。對診斷不肯定者應定期隨訪。
緩解方法
以治療原發病為主,不應周旋於嗜酸粒細胞的殺傷。
原發性高嗜酸粒細胞綜合徵可用腎上腺皮質激素治療,以減少嗜酸粒細胞的浸潤。必要時加用羥基脲、長春新鹼或苯丁酸氮芥。對難治性或不能耐受上述治療者alpha;干擾素可能有效。
保持室內清潔。蒼蠅、蟑螂等可傳播腸道傳染病。因此,消滅蒼蠅與蟑螂也是預防夏季腸道傳染病的重要措施之一。充足的睡眠和豐富的營養有助於增強體力,也有助於預防夏季腸道傳染病。此外,夏季也要積極鍛鍊多飲水,良好的體能狀態可以增強人體免疫力。